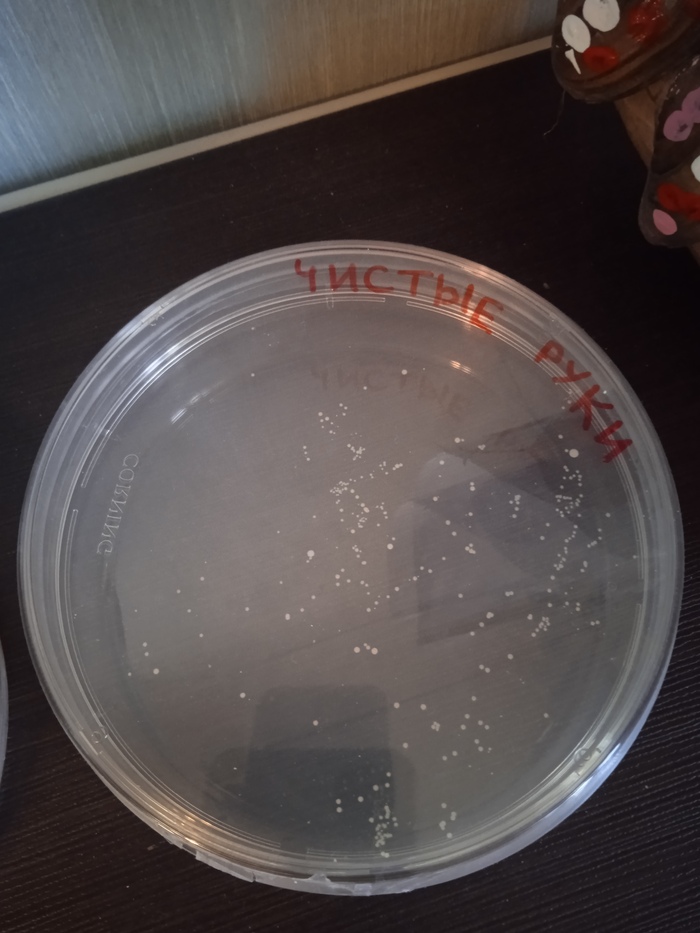
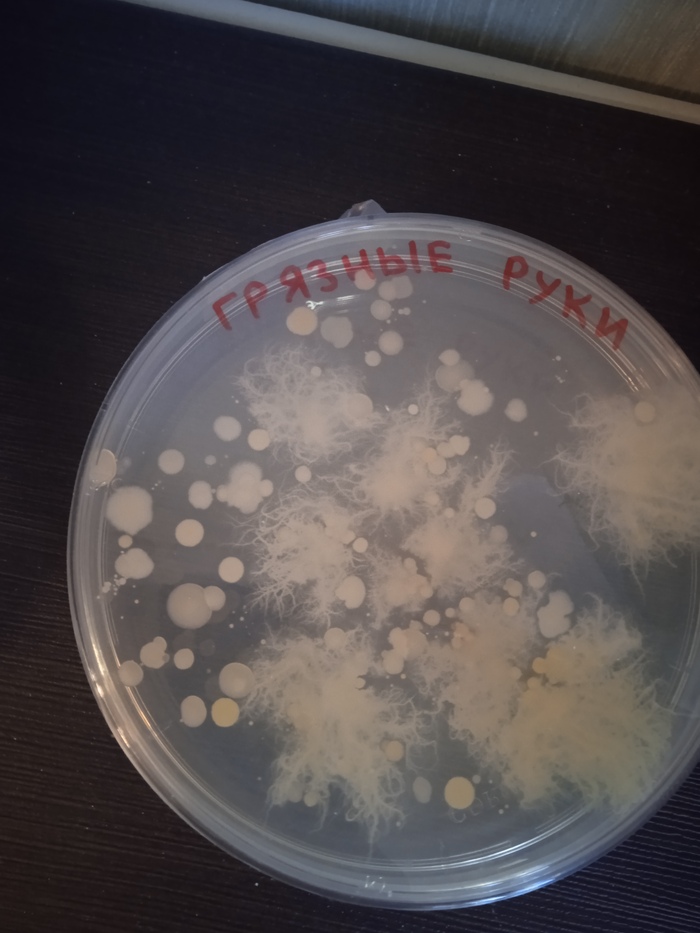
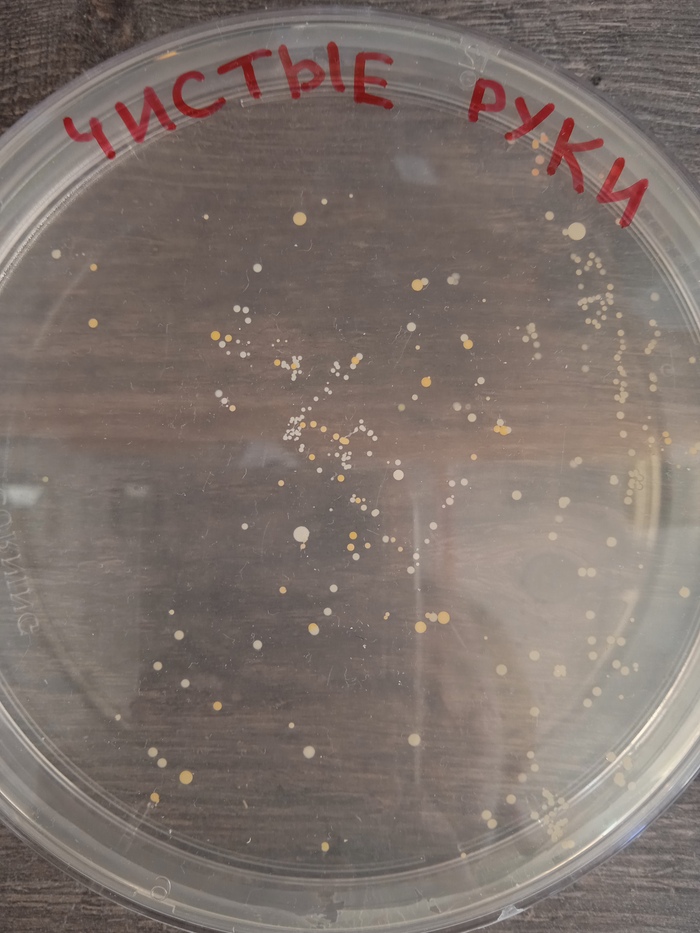
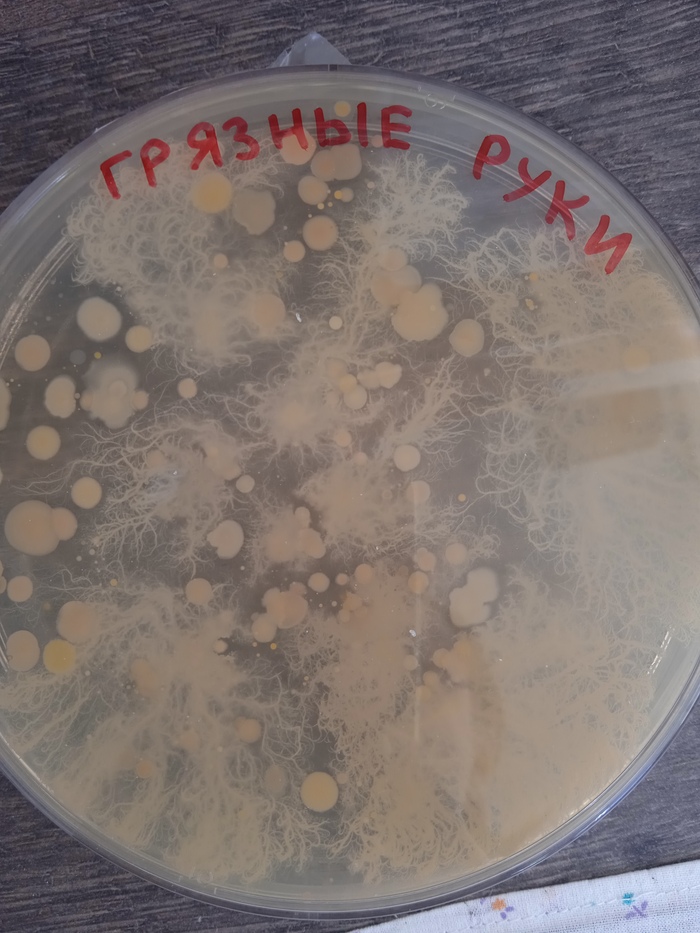
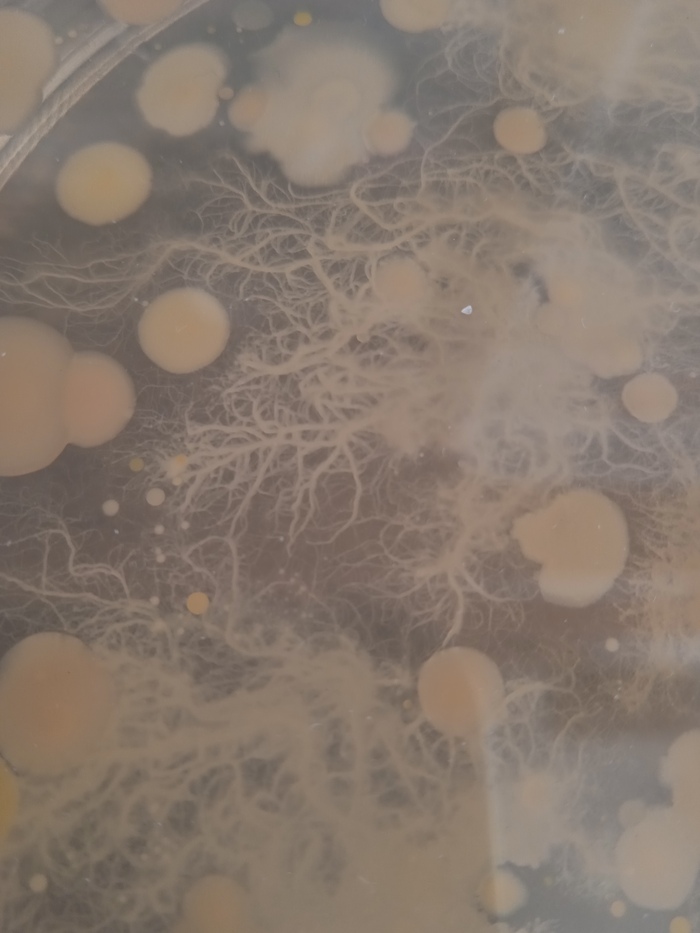
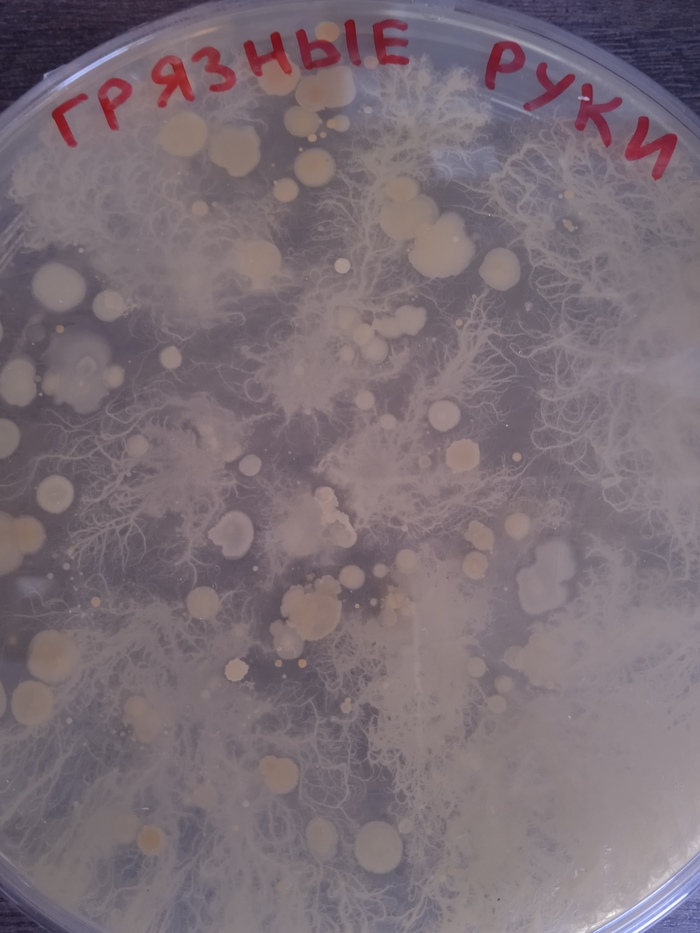
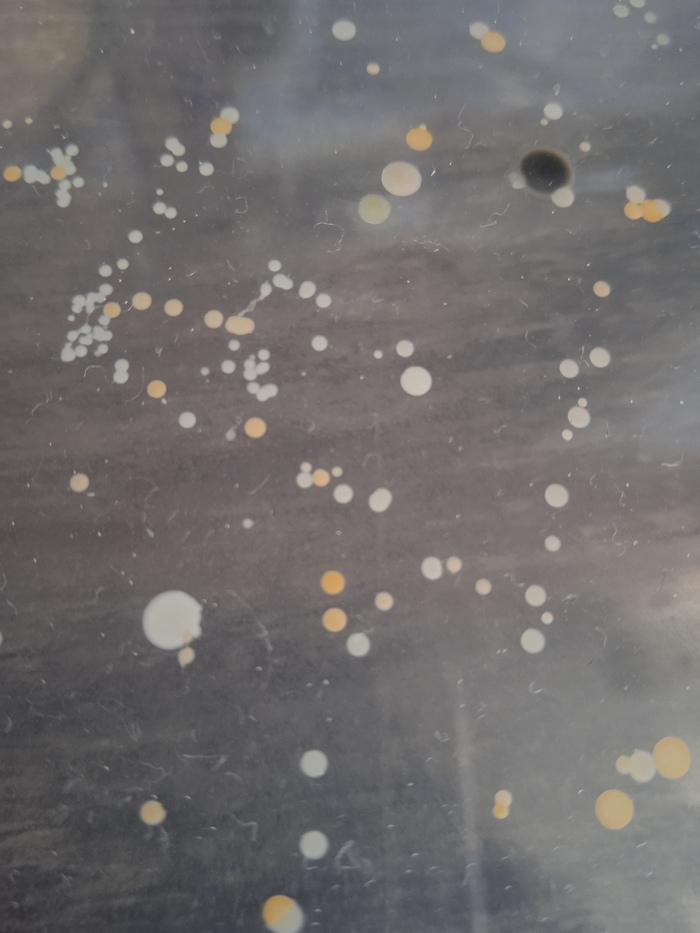

Что вырастет, если не помыть руки?1
Сыну 5 лет. Руки после прогулки мыть не очень любил, постоянно искал разные отмазки. И я решила живьём показать ему, какая живность водится на немытых руках.
Мы взяли две чашки Петри с питательным желе для бактерий. Одну чашку сын погладил грязными влажными руками после прогулки. Потом хорошо вымыл руки с мылом, и приложил ладонь ко второй чашке.
На фото - что у нас выросло на чашках через три дня. На чашке "грязные руки" много всего разного, в то время как чашка "чистые руки" совершенно пустая.
День 4. Микроорганизмы на "грязной" чашке сильно разрослись, а на "чистой" появилось немного белых колоний бактерий.
День 6. "Грязная" чашка почти полностью заросла, а некоторые колонии на белой чашке окрасились в оранжевый цвет. Подозреваю, что где-то тут есть золотистый стафилококк. Если тут есть специалисты, подскажете, что именно могло у нас вырасти?
День 10. Внешний вид чашек уже не меняется, поэтому эксперимент можно считать оконченным. Колонии на "чистой" чашке за последние 4 дня стали ярче, а также появилась одна черная плесневая колония.
Сын сделал выводы :) Теперь у него есть наглядное представление о том, кто и в каких количествах живёт на грязных руках. Руки после прогулки стал мыть без вопросов.
Если кому интересна тема таких околонаучных занятий с маленькими детьми - я веду Телеграм-канал (там выкладываю больше, чем на Пикабу, туда мне проще писать). Мы наблюдаем за головастиками, за улитками, делаем краски из капусты и другие подобные занятия).
https://t.me/mom_and_kids_creative